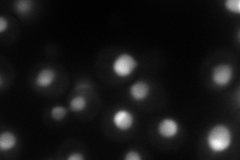
YMR128W
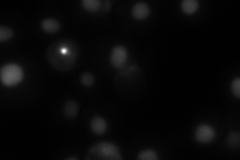
YMR128W
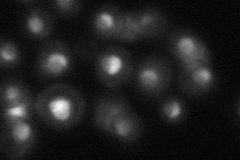
YMR128W
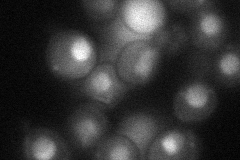
YMR128W

View description
Essential DEAH-box ATP-dependent RNA helicase specific to the U3 snoRNP, predominantly nucleolar in distribution, required for 18S rRNA synthesis
Localization:
Intensity:
Fold change:
Significance:
-
C’ GFP library in SD

nucleolus64.56 -
N' NOP1pr-GFP in SD
nucleus,nucleolus129.105 -
N' TEF2pr-mCherry in SD
nucleus124.551 -
N' NATIVEpr-GFP in SD
nucleus,nucleolus51.2548 -
N' TEF2pr-VC and Cyto-VN in SD
nucleus,nucleolus41.9683 -
C’ GFP library in SD+DTT

nucleolus27.350.42Yes -
C’ GFP library in SD+H2O2

nucleolus55.80.86No -
C’ GFP library in Starvation Media

nucleolus22.360.34Yes -
C’ GFP library on the background of Pup2-DaMP

nucleolus -
C’ GFP library on the background of CCT mutant

nucleolus58.18190.901004No
